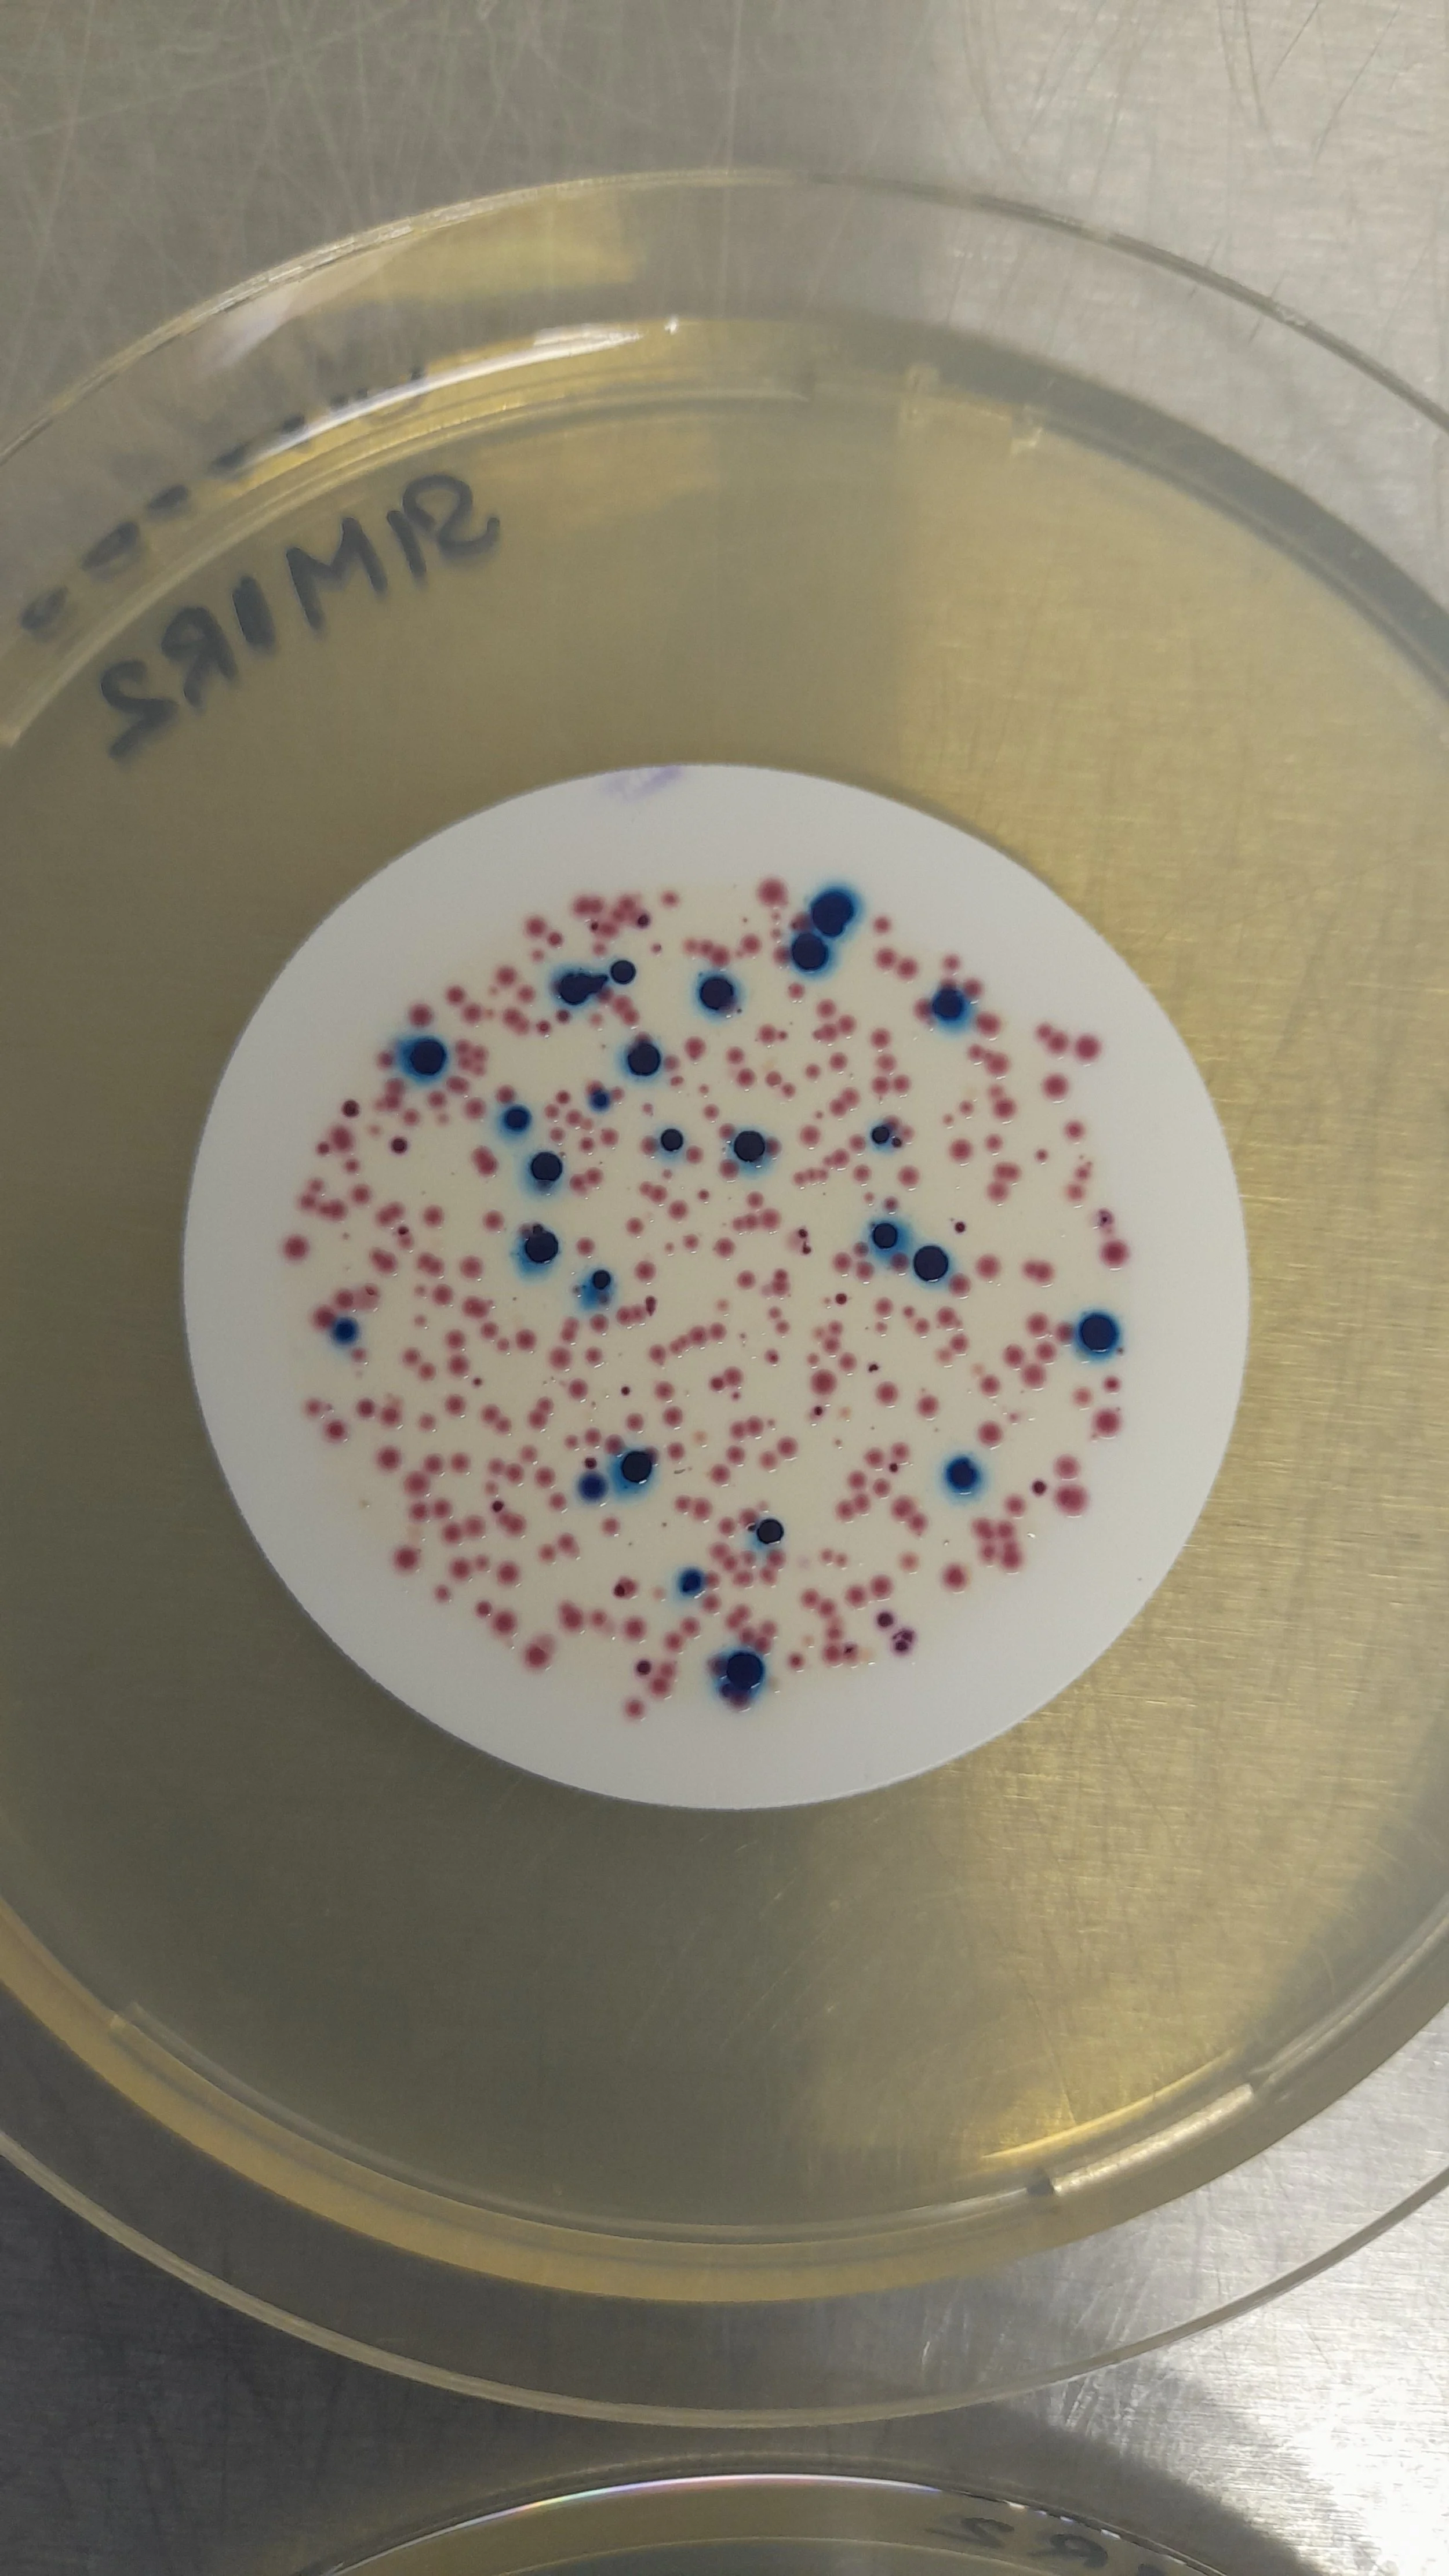
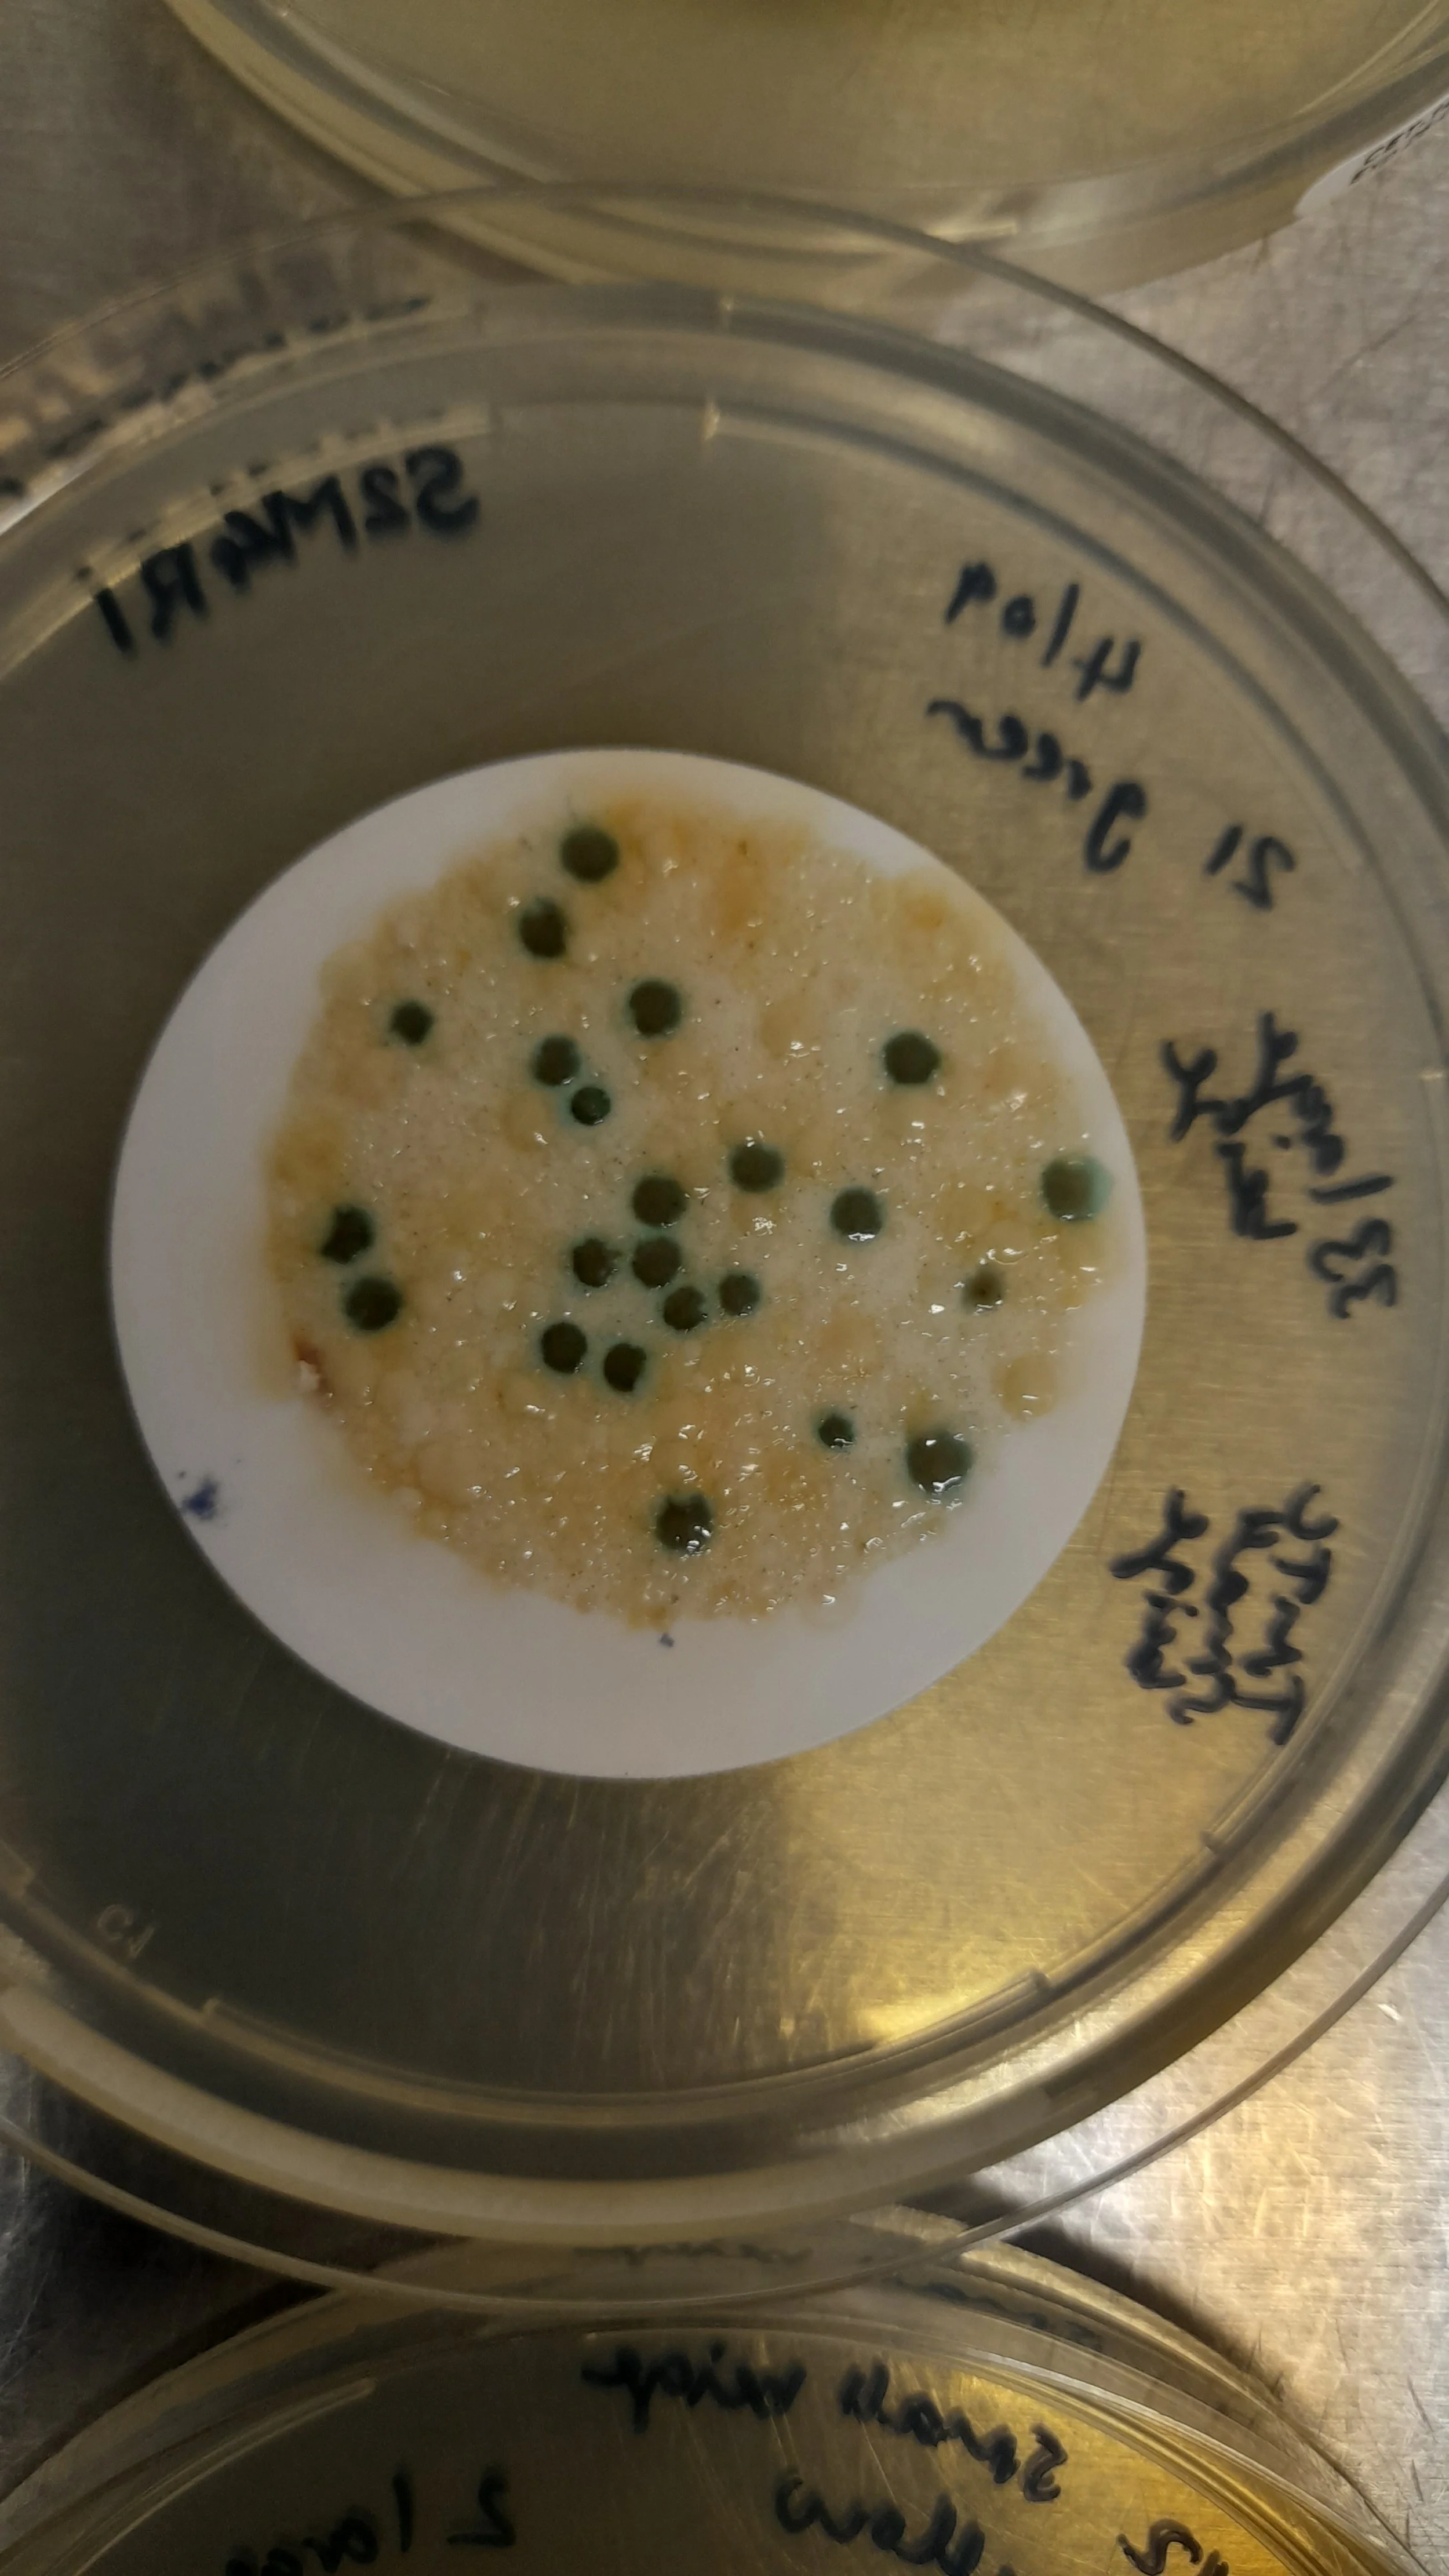

Water Monitoring with Biotech startup
ASCUS is working in partnership with long-term ASCUS Lab users and biotech start-up Cexal Ltd on a new research project.
Cexal has been based in the ASCUS Lab since 2023. Their goal is to create fast, easy-to-use testing tools that can detect harmful microbes in under 30 minutes—much quicker than many current testing methods.
One of their technologies, called Rapid Path, has received funding from Innovate UK to explore how well it can be used to check the quality of environmental water. At present, the system can detect E. coli in laboratory conditions. This project aims to find out whether the test also works reliably in real-world environments, where water quality and composition can vary widely.
ASCUS is leading the design of a sampling programme to test the technology across different types of water sources. This work helps ensure the test remains accurate and dependable when used outside the lab, in practical, everyday settings.
In 2025, we identified and selected a range of sites around the Edinburgh area with different expected levels of contamination. Samples from these locations were first tested in the lab to understand how the system performs, before moving on to testing directly in the field which will take place in 2026.

Identifying which bacteria are present in selected sites using conventional detection methods to confirm the target bacteria for the test.
